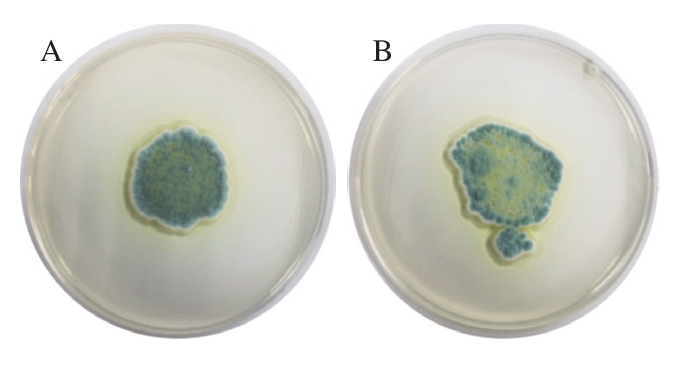
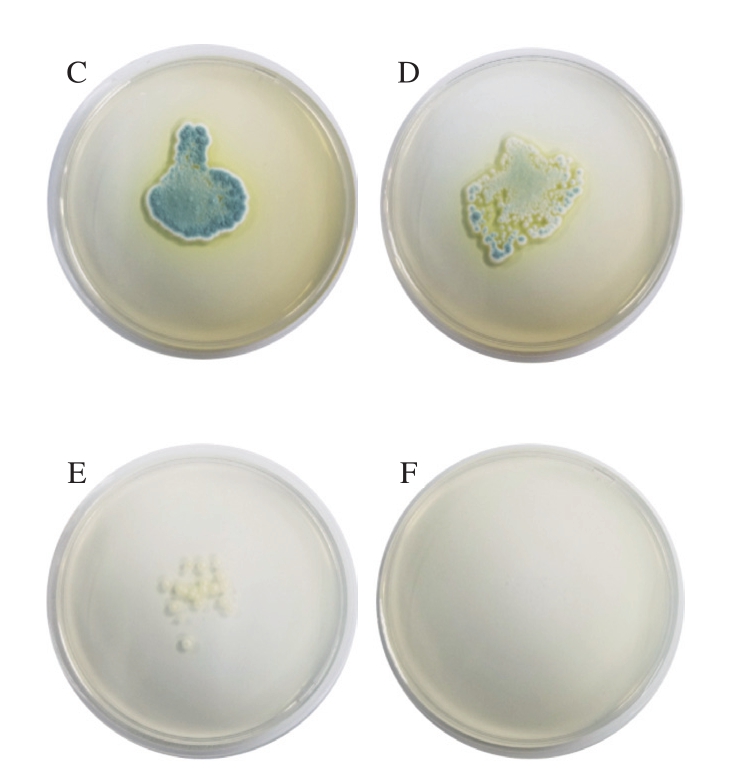

稻谷作为我国主要储备粮之一,在收获与储运过程中易受到微生物的侵染而产生霉变,其侵染霉菌种类较多,主要是曲霉属和青霉属[1-2]。粮食霉变的实质是霉菌分解利用粮食中的有机物质进行生长和产毒活动[3]。据统计,全球每年因霉变和储粮害虫造成的粮食产后损失占粮食总量的10%~15%[4]。霉变会导致粮食品质下降,一方面影响水稻的感官特性和营养价值;另一方面霉菌的次生代谢产物给人和牲畜带来安全隐患[5]。灰绿曲霉是稻谷储藏过程中的优势霉菌之一,在储藏后期过程中,优势霉菌会演替为储藏霉菌[6]。
随着人们对食品安全与健康日益重视,天然植物精油在食品行业中的应用已经成为近年来的研究热点。紫苏作为唇形科草本植物,是我国卫生部首批颁布的药食两用植物之一,其茎叶中富含精油;紫苏精油(perilla essential oil,PEO)的主要成分为紫苏醛[7-8]。紫苏醛别名二氢枯茗醛,分子式为C10H14O,是一种具有辛香香气的光学活性萜类化合物。常温下,PEO是一种无色至浅黄色液体,不溶于水,溶于乙醇、氯仿、苯和石油醚等。PEO具有重要的生理保健功能,如抗菌、抗癌、抗氧化、抗衰老、舒张血管等,在食品工业、化妆品、医药、烟草等行业均有广泛应用[9];无论在食品的增香、防腐、抗菌、增色方面,还是在特效药物的研发和临床治疗的推广方面,均带来了可观的经济效益,具有重大的科研价值[10]。研究表明,将PEO应用于仓储玉米中可以预防玉米品质下降[11]。已有研究利用适量浓度PEO提高稻谷在储藏期间的整精米率,并预防不完善粒率及微生物数量的增长[12-14];紫苏醛与柠檬烯对丝状真菌有协同抑制作用[15]。还有研究将不同植物精油应用于大米防霉,发现复配精油对青霉和黑曲霉的抑菌效果极佳[16]。基于PEO在食品中微生物抑制领域的应用,本实验主要测定了PEO对灰绿曲霉的最小抑制浓度(minimum inhibitory concentration,MIC),研究不同剂量PEO的抑菌活性,探讨PEO抑制灰绿曲霉的抑菌机理,为PEO对灰绿曲霉的控制提供理论参考。
1 材料与方法
1.1 菌株、材料与试剂
灰绿曲霉由南京财经大学食品科学与工程学院重点实验室储藏,经28S rDNA测定为灰绿曲霉。
马铃薯葡萄糖琼脂培养基(potato dextrose agar,PDA)北京陆桥技术股份有限公司;马铃薯葡萄糖水(potato dextrose broth,PDB)培养基 青岛海博公司;PEO(其组分经气相色谱-质谱测定,主要含有38.85%的1-环己烯-1-甲醛、9.84%的1-(2,5-二甲基苯基)-乙酮、9.72%的8-羟基羧基丙酮、9.19%的庚-2-烯-2-甲醛、8.99%的辛烷、4.51%的双环辛烷和3.85%的庚-2-酮)南京丁贝生物技术公司;其余试剂均为分析纯。
1.2 仪器与设备
酶标仪 美国伯腾仪器有限公司;隔水式恒温培养箱 上海精宏实验设备公司;TM3000扫描电子显微镜 日本株式会社日立制作所;Scope A1正置荧光显微镜 德国蔡司公司;傅里叶变换红外光谱仪德国布鲁克公司;BD FACSVerse流式细胞仪 上海微速生物科技有限公司;UV-1700紫外-可见分光光度计日本岛津公司。
1.3 方法
1.3.1 菌株培养及孢子液的制备
将灰绿曲霉接种于新鲜的PDA培养基上,置于30 ℃恒温培养箱中培养3 d,待霉菌生长良好再次接种于新鲜的PDA培养基上,重复数次后,将霉菌接种于PDB培养液中,于30 ℃培养3~5 d,将菌液与灭菌后的30%(体积分数)甘油以体积比1∶1混合后保存在-70 ℃冰箱中。活化时将冻存的菌液解冻后以1%(体积分数)接种于马铃薯葡萄糖水培养基中,30 ℃培养1 d,备用。
灰绿曲霉孢子液的制备:将灰绿曲霉接种PDA培养基上30 ℃恒温培养3 d,用无菌水冲洗霉菌,经纱布过滤制得孢子悬浮液,并用血球计数板在400 倍显微镜下观察计数;-4 ℃暂存,备用。
1.3.2 PEO对灰绿曲霉MIC测定
将PEO溶于质量分数为5%的Tween-80溶液中得到初始剂量为4 μL/mL的溶液。调整活化好菌液的浓度,按体积比1∶1加入PEO溶液中进行2 倍稀释后,分别得到终剂量为2、1、0.5、0.25、0.125、0.062 5 μL/mL和0.031 25 μL/mL的体系,并使初始霉菌孢子数为5×105 CFU/mL,以不加PEO的菌液为阴性对照,以培养基为阳性对照。于恒温培养箱中30 ℃培养,分别在0、12、24、36、48、60 h和72 h时检测各剂量的OD600 nm,其中与阳性对照组OD600 nm相近的最低PEO剂量即为PEO对其的MIC[17]。
1.3.3 PEO对灰绿曲霉最小杀菌浓度测定
按上述方法分别制得PEO剂量为4、2、1、0.5 μL/mL和0.25 μL/mL的体系,并使灰绿曲霉孢子数为5×105 CFU/mL,以不加PEO的菌液为对照。置于30 ℃培养箱中处理24 h后,吸取50 μL处理好的菌液于PDA培养基上,30 ℃培养5 d后,观察其生长情况,拍照记录[18]。
1.3.4 PEO对菌丝生长的抑制作用测定
通过测定精油对霉菌菌丝生长的抑制率来评价精油对霉菌的抑菌活性[19]。用上述办法配制不同剂量的PEO加入PDB培养基中,并调整50 mL总体系中孢子终浓度为5×105 CFU/mL;没有PEO处理的样品为对照组。在30 ℃下培养3 d后收集菌丝体,在60 ℃下干燥24 h并称其干基质量;与对照组相比,按式(1)计算菌丝生长的抑制率。
式中:mC是对照板中的菌丝体平均质量/g;mS是含有PEO培养基中的菌丝体平均质量/g。
1.3.5 PEO对孢子萌发的抑制作用测定
根据林春花等测定真菌孢子萌发的方法[20]稍作调整:在培养皿中用PDA培养基培养5 d,用无菌水冲洗过滤分别制得两种霉菌孢子悬浮液;将50 μL的霉菌孢子悬浮液滴加到含0(对照)、0.25、0.5 μL/mL和1 μL/mL PEO的PDB培养基中。通过显微镜观察,当孢子萌芽的长度比孢子直径长时,即判定为孢子萌发。当对照组的孢子萌发量约达到总孢子量的80%以上时,将乳酚棉蓝滴入培养基中以终止孢子萌发。记录萌发和未萌发孢子的数量并计算孢子萌发的百分比,每次测定处理约200 个单孢子,实验重复3 次。
1.3.6 质膜中麦角固醇质量分数的测定
灰绿曲霉麦角固醇质量分数的测定方法如下:将灰绿曲霉孢子悬浮液按5×105 CFU/mL接种于含0、0.25、0.5 μL/mL和1 μL/mL PEO的PDB培养基中,30 ℃培养5 d,收集菌丝体并用蒸馏水洗涤两次。为避免影响麦角固醇在质膜中的含量,将菌丝体样品用滤纸过滤。向每个样品中加入5 mL质量分数25%的氢氧化钾醇溶液,漩涡混合5 min,然后在85 ℃下孵育4 h。加入2 mL无菌蒸馏水和5 mL正庚烷,然后漩涡振荡2 min。收集正庚烷层,并通过UV-1700紫外-可见分光光度计在230~300 nm之间扫描。正庚烷层中麦角固醇(282 nm)和麦角固醇的中间产物(脱氢麦角固醇(230~282 nm))存在导致产生特征曲线[21]。将未经PEO处理的样品视为对照。麦角固醇质量分数按式(2)、(3)计算。

式中:ω脱氢麦角固醇为脱氢麦角固醇质量分数/%;ω麦角固醇为麦角固醇质量分数/%;m菌丝体为菌丝体湿质量/g。
1.3.7 扫描电子显微镜观察PEO对灰绿曲霉形态的影响
将灰绿曲霉孢子液在PDB中培养3 d后,4 000 r/min离心10 min,吸去上清液并收集菌丝体,磷酸盐缓冲液(phosphate buffered saline,PBS)反复冲洗除去培养基,用剂量为0、0.25、0.5 μL/mL和1 μL/mL的PEO于37 ℃处理24 h后,PBS反复冲洗除去PEO溶液。用质量分数为2.5%的戊二醛溶液浸泡2 h固定,用PBS漂洗3 次,接下来用体积分数为30%、50%、70%、80%、90%、100%的乙醇梯度脱水各15 min,离心后固定在镜片上,放入通风橱风干,喷金后镜检拍照[22]。
1.3.8 灰绿曲霉线粒体ATP酶活力的测定
用上述方法收集0、0.25、0.5 μL/mL和1 μL/mL的PEO处理的菌丝体,重悬于10 mL含有50 mmol/L Tris(pH 7.5)、2 mmol/L乙二胺四乙酸、1 mmol/L苯基甲磺酰氟的缓冲液中后,将上清液转移到新的离心管中,以10 000×g离心30 min,通过质量分数2%的葡萄糖溶液破坏细胞获得线粒体,并以2 000×g离心5 min,然后以10 000×g离心30 min。最后,将线粒体重悬于10%初始体积的缓冲液中并储存于4 ℃备用[23]。使用A016-1-1 ATP酶试剂盒检测PEO处理灰绿曲霉中的线粒体ATP酶活力。
1.3.9 流式细胞术测定灰绿曲霉孢子完整性
将灰绿曲霉孢子液在PDB培养基中培养至对数期,5 000 r/min离心10 min,用PBS冲洗3 次,分别用剂量为0.25、0.5 μL/mL和1 μL/mL的PEO在振荡培养器中30 ℃处理孢子24 h,空白组为对照。用PBS冲洗3 次,随后将孢子重悬于PBS中,用PI染液染色30 min,用流式细胞仪检测孢子完整性。
1.3.10 灰绿曲霉菌丝体的傅里叶变换红外光谱测定
按上述方法,将灰绿曲霉菌丝体分别用0、0.25、0.5 μL/mL和1 μL/mL的PEO处理24 h后,用PBS冲洗3 次除去PEO溶液后,置于冷冻干燥机中冻干。将所得冻干菌丝体研钵磨粉,将菌丝粉末与光谱级溴化钾混合均匀制片,在傅里叶变换红外光谱中检测,测试的波数范围为400~4 000 cm-1。每组实验重复5 次。
1.4 数据处理与分析
每个实验至少重复3 次,采用Origin 2018软件处理所得数据并绘制图表。
2 结果与分析
2.1 PEO对灰绿曲霉的MIC

图1 不同剂量PEO处理对灰绿曲霉的生长抑制作用
Fig.1 Growth inhibition of Aspergillus glaucus by different concentrations of PEO
从图1可以看出,不同剂量的PEO溶液对灰绿曲霉均有一定的抑制效果,随着PEO剂量的增加,OD600 nm逐渐下降,PEO对灰绿曲霉的抑制作用随PEO剂量的增加而增强,表现出一定的剂量效应;当精油剂量在0.5 μL/mL及以上时,灰绿曲霉受抑制效果明显,由此可推测,PEO对灰绿曲霉的MIC为0.5 μL/mL。
2.2 PEO对灰绿曲霉的最小杀菌浓度
从图2可以看出,随PEO剂量提高,灰绿曲霉在PDA培养基上的生长明显减少。1 MIC PEO处理过的灰绿曲霉孢子液可以在新鲜的PDA培养基上生长,可以推测1 MIC可以抑制或杀死部分孢子,却并不能杀死全部孢子。而当PEO的剂量为4 μL/mL时,灰绿曲霉在PDA培养基上没有生长,由此可以推测PEO对灰绿曲霉的最小杀菌剂量为4 μL/mL,灰绿曲霉孢子经8 MIC PEO处理后完全失活,且PEO对灰绿曲霉的损伤不可逆。

图2 不同剂量PEO处理对灰绿曲霉在PDA培养基上生长的影响
Fig.2 Effects of different concentrations of PEO on the growth of Aspergillus glaucus on potato dextrose agar medium
A.0 MIC;B.0.5 MIC;C.1 MIC;D.2 MIC;E.4 MIC;F.8 MIC。
2.3 PEO对灰绿曲霉菌丝生长的影响

图3 不同剂量PEO处理后灰绿曲霉的菌丝干质量
Fig.3 Dry mycelial mass of Aspergillus glaucus treated with different concentrations of PEO
从图3可以看出,随着PEO剂量的增加,灰绿曲霉菌丝干质量明显减少。与对照组对比,在0.25、0.5 μL/mL和1 μL/mL剂量下灰绿曲霉菌丝抑制率分别为81.75%、88.05%、93.07%,PEO抑制灰绿曲霉菌丝体生长的效果明显;由此可见,PEO可以高效抑制PDB中灰绿曲霉孢子生长为成熟的菌丝。
2.4 PEO对灰绿曲霉孢子萌发的影响

图4 不同剂量PEO处理对孢子萌发的影响
Fig.4 Inhibitory effect of different concentrations of PEO on spore germination
如图4所示,对照组在6、9 h和12 h时的孢子萌发率分别为44%、72.67%和97.67%,在培养12 h后几乎所有孢子都萌发;当PEO剂量达到1 μL/mL时,处理过的灰绿曲霉在6、9 h和12 h的孢子萌发率分别为0%、5.33%和11.77%。PEO处理过的孢子在培养6 h时均没有萌发;随着PEO剂量的增加,灰绿曲霉的孢子萌发率明显降低;当PEO剂量达到1 MIC和2 MIC时,孢子萌发率大大减少。
2.5 PEO对灰绿曲霉质膜中麦角固醇质量分数的影响
麦角固醇是丝状真菌细胞壁的主要成分,被认为是评价不同基质中真菌生物量并维持膜完整性的标准[24]。麦角固醇除了调节细胞膜的流动性、不对称性和完整性外,还有助于维持膜结合酶的正常功能和质膜蛋白的定位。由图5可知,当PEO剂量为0、0.25、0.5 μL/mL和1 μL/mL时,质膜中麦角固醇质量分数分别为80.96%、16.37%、11.13%和8.03%。随着灰绿曲霉中麦角固醇质量分数的减少,PEO的抑制作用可能会影响某些膜结合蛋白的完整性和功能,导致渗透性增强并破坏霉菌细胞生长。

图5 不同剂量PEO处理后霉菌中麦角固醇质量分数
Fig.5 Content of ergosterol in Aspergillus glaucus mycelia treated with different concentrations of PEO
2.6 PEO对灰绿曲霉细胞形态的影响

图6 经不同剂量PEO处理后的霉菌扫描电子显微镜照片
Fig.6 SEM images of Aspergillus glaucus mycelia treated by different concentrations of PEO
A.空白对照组;B.0.25 μL/mL;C.0.5 μL/mL;D.1 μL/mL。
由图6可知,空白对照组灰绿曲霉圆润饱满、菌丝形态完整、表面光滑。而用0.25 μL/mL剂量的PEO处理后,灰绿曲霉表面变得不光滑,有细微凹陷产生,且有些菌丝体出现干瘪与褶皱,表明霉菌受到一定损伤;当剂量增加到0.5 μL/mL时,菌丝体严重扭曲变形,灰绿曲霉表面出现明显的褶皱与凹陷;当PEO剂量增加到1 μL/mL时,菌丝体出现大量孔洞,由此推测可能导致菌丝体内含物流出,细胞通透性改变[25]。
2.7 PEO对灰绿曲霉线粒体ATP酶活力的影响

图7 不同剂量PEO处理对灰绿曲霉细胞线粒体ATP酶活力的影响
Fig.7 Different concentrations of PEO inhibit mitochondrial ATPase activity in Aspergillus glaucus cells
由图7可知,当PEO剂量增加,灰绿曲霉的线粒体ATP酶活力随之降低。当PEO剂量为1/2 MIC时,其抑制效果并不明显;当PEO剂量增加到1 MIC和2 MIC时可以有效地抑制线粒体ATP酶的活性。PEO剂量为0.5、1 MIC和2 MIC时,灰绿曲霉的ATP酶活力抑制率分别为15.39%、53.60%和67.05%。结果表明PEO可以有效抑制灰绿曲霉线粒体ATP酶活力。线粒体ATP酶是细胞代谢所必需的,线粒体ATP酶的消耗将导致细胞内ATP水平降低,并导致细胞死亡[26]。作为ATP的主要来源,线粒体ATP酶的抑制将导致质膜ATP酶的抑制并进一步降低培养基酸化的pH值。这与细胞膜渗透性和细胞膜结构的破坏有关。
2.8 PEO对灰绿曲霉孢子细胞膜完整性的影响

图8 不同剂量PEO处理对灰绿曲霉孢子细胞膜完整性的影响
Fig.8 Effect of different concentrations of PEO on cell membrane integrity
A.PI染色细胞数量;B.PI染料细胞渗透率。
如图8所示,经不同剂量PEO处理后,PI标记的灰绿曲霉的荧光水平发生明显变化,随着PEO剂量的增加,被染色的细胞数量增加。当用0.5、1 MIC和2 MIC剂量的PEO处理时,灰绿曲霉细胞渗透率较对照组分别增加55.11%、63.96%和69.91%。PI是一种不渗透膜的染料,当细胞膜通透性发生变化时,PI才可以进入细胞。当PEO剂量增加到2 MIC时,PI染色细胞数量明显增加,这也进一步验证了PEO对灰绿曲霉细胞膜功能的影响。
2.9 PEO对灰绿曲霉菌丝体傅里叶变换红外光谱的影响

图9 不同剂量PEO处理灰绿曲霉的傅里叶变换红外光谱图
Fig.9 FTIR spectra of Aspergillus glaucus mycelia treated with different concentrations of PEO
由图9可知,不同剂量PEO处理后的菌丝体经傅里叶变换红外光谱扫描后,在不同的波数具有不同的表征。随着PEO剂量从0增加至2 MIC,在不同的特征峰均呈现出不同程度的变化。波数3 384 cm-1附近的吸收峰反映羟基(—OH)伸缩振动,波数2 924 cm-1附近的吸收峰反映甲基和亚甲基碳氢键(C—H)伸缩振动,1 083 cm-1附近的吸收峰反映芳香族面内弯曲。在波数1 548~1 744 cm-1范围内出现的吸收峰归属于芳香族骨架的动态振动,吸收峰存在一定的差异,1 548 cm-1附近为苯环的碳骨架振动。结果表明PEO可能会影响灰绿曲霉菌丝体化合物(如脂质、蛋白质和碳水化合物等)的变化。
3 讨 论
近年来,鉴于化学合成杀菌剂与防腐剂存在的安全隐患,亟需开发高效抑菌且环保的食品防护剂,其中天然植物代谢产物已被广泛研究用于抗真菌污染,植物代谢产生的芳香挥发性产物作为高效率和低耐药性的环保型抗真菌剂具有很大的应用潜力与前景。
PEO作为绿色、健康的天然抑菌剂,越来越受到广泛的关注和青睐。本研究显示PEO对灰绿曲霉的菌丝体生长、孢子萌发、麦角固醇质量分数及线粒体ATP酶活力均有一定程度的抑制效果。当PEO剂量在1 MIC及以上时,霉菌菌体变形,细胞表面完整性与通透性改变。由此推测PEO的抑菌机理可能与其理化性质有关[27],PEO可能作用于霉菌细胞,导致细胞膜特性的改变,从而影响菌体的生长。PEO还可能进一步穿透细胞膜,进入细胞内部,降低细胞内ATP水平,从而降低霉菌细胞整体的活性[28-29]。
精油的抑菌机制通常归因于一些低分子质量和高度亲脂性成分对膜的破坏,这些成分可能会穿透细胞质膜并最终导致真菌细胞死亡[30]。在一项评估肉桂醛对枯萎镰孢镰刀菌效果的研究中发现了明显的细胞质膜破裂[31]。因此,精油能够对细胞膜造成一定程度的损害,破坏细胞膜完整性,从而阻碍细胞生长。
本实验将PEO作用于灰绿曲霉,结果表明不同剂量的PEO对灰绿曲霉均有一定的抑制作用,且一定程度上PEO对这种霉菌的抑菌效果与其剂量成正比。从灰绿曲霉的麦角固醇含量和PI染色结果看,PEO破坏了霉菌孢子的细胞膜完整性;从扫描电子显微镜的结果可以看出PEO处理后霉菌细胞变形,细胞明显受损。由此可知,PEO对灰绿曲霉的作用方式主要是通过影响麦角固醇的合成,使细胞膜通透性增加,导致内含物流出,使线粒体ATP酶活性降低,破坏其表面官能团结构,最终达到抑菌效果。
[1]奚萌, 周建新, 葛志文, 等.稻谷粮堆储藏过程中微生物区系演替规律研究[J].中国粮油学报, 2019, 34(5): 90-94; 100.DOI:10.3969/j.issn.1003-0174.2019.05.017.
[2]葛志文, 方宝庆, 邱伟芬, 等.储藏稻谷优势霉菌的分离鉴定及特征分析[J].粮油食品科技, 2019, 27(3): 78-83.DOI:10.16210/j.cnki.1007-7561.2019.03.013.
[3]胡元森, 陈静, 李翠香, 等.几种储粮霉菌脱氢酶活性测定方法的建立[J].食品科学, 2012, 33(13): 207-221.
[4]李月, 李荣涛.谈储粮微生物的危害及控制[J].粮食储藏, 2009,38(2): 16-19.DOI:10.3969/j.issn.1000-6958.2009.02.004.
[5]和肖营, 都立辉, 陈达民, 等.东北稻谷储藏期间霉菌生长趋势研究[J].粮食储藏, 2018, 47(1): 28-31; 36.DOI:10.3969/j.issn.1000-6958.2018.01.008.
[6]周涛.储藏稻谷中霉菌的生长演替规律及霉变稻谷的品质研究[D].武汉: 武汉轻工大学, 2018: 17-20.
[7]李娜.紫苏精油提取及其防腐复合材料的制备和性能研究[D].太原: 中北大学, 2018: 15-16.
[8]林淼, 周美玲, 霍永久, 等.紫苏叶挥发油及紫苏醛、柠檬烯对小鼠生长性能、血液指标及粪便菌群的影响[J].中国饲料, 2014(22):26-28; 32.
[9]薛山.紫苏精油的研究新趋势[J].中国食品添加剂, 2011(1):199-204.DOI:10.3969/j.issn.1006-2513.2011.01.032.
[10]王宇新.紫苏精油对玉米象成虫的生物活性及酶活力的影响[D].长春: 东北师范大学, 2009: 5-7.
[11]贾佼佼, 李艳, 苗明三.紫苏的化学、药理及应用[J].中医学报,2016, 31(9): 1354-1356.DOI:10.16368/j.issn.1674-8999.2016.09.381.
[12]袁康, 陆佳俊, 都立辉, 等.紫苏精油对短期温度变化稻谷的品质保持研究[J].粮食储藏, 2019, 48(5): 25-29.
[13]韦保耀, 黄丽, 滕建文, 等.紫苏香气的化学成分分析及评价[J].食品科学, 2007, 28(3): 301-305.DOI:10.3321/j.issn:1002-6630.2007.03.073.
[14]FERREIRA F D, KEMMELMEIER C, ARROTÉIA C C, et al.Inhibitory effect of the essential oil of Curcuma longa L.and curcuminon aflatoxin production by Aspergillus flavus Link[J].Food Chemistry,2013, 136(2): 789-793.DOI:10.1016/j.foodchem.2012.08.003.
[15]MCGEADY P, WANSLEY D, LOGAN D A.Carvone and perillaldehyde interfere with the serum-induced formation of filamentous structures in Candida albicans at substantially lower concentrations than those causing significant inhibition of growth[J].Journal of Natural Products, 2002, 65(7): 953-955.DOI:10.1021/np010621l.
[16]卢锟, 唐雅珂, 龚吉军, 等.不同植物精油对大米青霉和黑曲霉的抑菌效果[J].食品工业科技, 2020, 41(3): 110-113; 119.DOI:10.13386/j.issn1002-0306.2020.03.020.
[17]周祺, 刘芳, 范晓然, 等.ε-聚赖氨酸对肠球菌的抑菌作用及机制[J].中国食品学报, 2018, 18(1): 65-72.DOI:10.16429/j.1009-7848.2018.01.009.
[18]THERY T, ARENDT E K.Antifungal activity of synthetic cowpea defensin Cp-thionin II and its application in dough[J].Food Microbiology, 2018, 73: 111-121.DOI:10.1016/j.fm.2018.01.006.
[19]TIAN J, ZENG X B, ZENG H, et al.Investigations on the antifungal effect of nerol against Aspergillus flavus causing food spoilage[J].The Scientific World Journal, 2013, 2013(3): 1-8.DOI:10.1155/2013/230795.
[20]林春花, 牟保辉, 刘文波, 等.疏水表面诱导橡胶树炭疽菌侵染结构的发育分化过程[J].植物保护学报, 2018, 45(3): 470-477.DOI:10.13802/j.cnki.zwbhxb.2018.2016207.
[21]TIAN J, BAN X Q, ZENG H, et al.The mechanism of antifungal action of essential oil from dill (Anethum graveolens L.) on Aspergillus flavus[J].PLoS ONE, 2012, 7(1): e30147.DOI:10.1371/journal.pone.0030147.
[22]谢强, 林玉桓, 苗淑萍, 等.香芹酚对大肠杆菌和金黄色葡萄球菌细胞膜的影响[J].食品工业科技, 2014, 35(23): 54-58.DOI:10.13386/j.issn1002-0306.2014.23.002.
[23]胡纯铿, 白凤武, 安利佳.细胞膜磷脂脂肪酸组成对自絮凝酵母质膜ATP酶响应酒精刺激的影响及其与菌体耐酒精的关系[J].生物工程学报, 2004, 20(5): 784-789.DOI:10.3321/j.issn:1000-3061.2004.05.029.
[24]HU Y C, ZHANG J M, KONG W J, et al.Mechanisms of antifungal and anti-aflatoxigenic properties of essential oil derived from turmeric(Curcuma longa L.) on Aspergillus flavus[J].Food Chemistry, 2017,220: 1-8.DOI:10.1016/j.foodchem.2016.09.179.
[25]周祺, 袁康, 刘芳, 等.香芹酚对阴沟肠杆菌的抑菌作用及机理[J].食品科学, 2019, 40(13): 22-27.DOI:10.7506/spkx1002-6630-20180630-540.
[26]PETRUSSA E, BERTOLINI A, KRAJŇÁKOVÁ J, et al.Isolation of mitochondria from embryogenic cultures of Picea abies (L.) Karst.and Abies cephalonica Loud.: characterization of a KATP+channel[J].Plant Cell Reports, 2008, 27(1): 137-146.DOI:10.1007/s00299-007-0436-2.
[27]AFANASYEVA M A, USTIUGOVA A S, GOLYSHEV S A,et al.Isolation of large amounts of highly pure mitochondria for“omics” studies[J].Biochemistry, 2018, 83(1): 76-85.DOI:10.1134/S0006297918010108.
[28]LI W T, FAN J X, LI W Z, et al.Inhibitory mechanism of different treated manure biogas slurry on some fungi[C]// Chengdu:International Conference on Materials for Renewable Energy &Environment, 2014: 1501-1504.
[29]刘淼, 陶能国, 许灵春, 等.柠檬醛对酸腐菌线粒体形态和功能的影响[J].食品科学, 2019, 40(17): 121-126.DOI:10.7506/spkx1002-6630-20181030-355.
[30]CHAO L K, HUA K F, HSU H Y, et al.Study on the antiinflammatory activity of essential oil from leaves of Cinnamomum osmophloeum[J].Journal of Agricultural and Food Chemistry, 2005, 53(18): 7274-7278.DOI:10.1021/jf051151u.
[31]XING F G, HUA H J, SELVARAJ J N, et al.Growth inhibition and morphological alterations of Fusarium verticillioides by cinnamon oil and cinnamaldehyde[J].Food Control, 2014, 46: 343-350.DOI:10.1016/j.foodcont.2014.04.037.